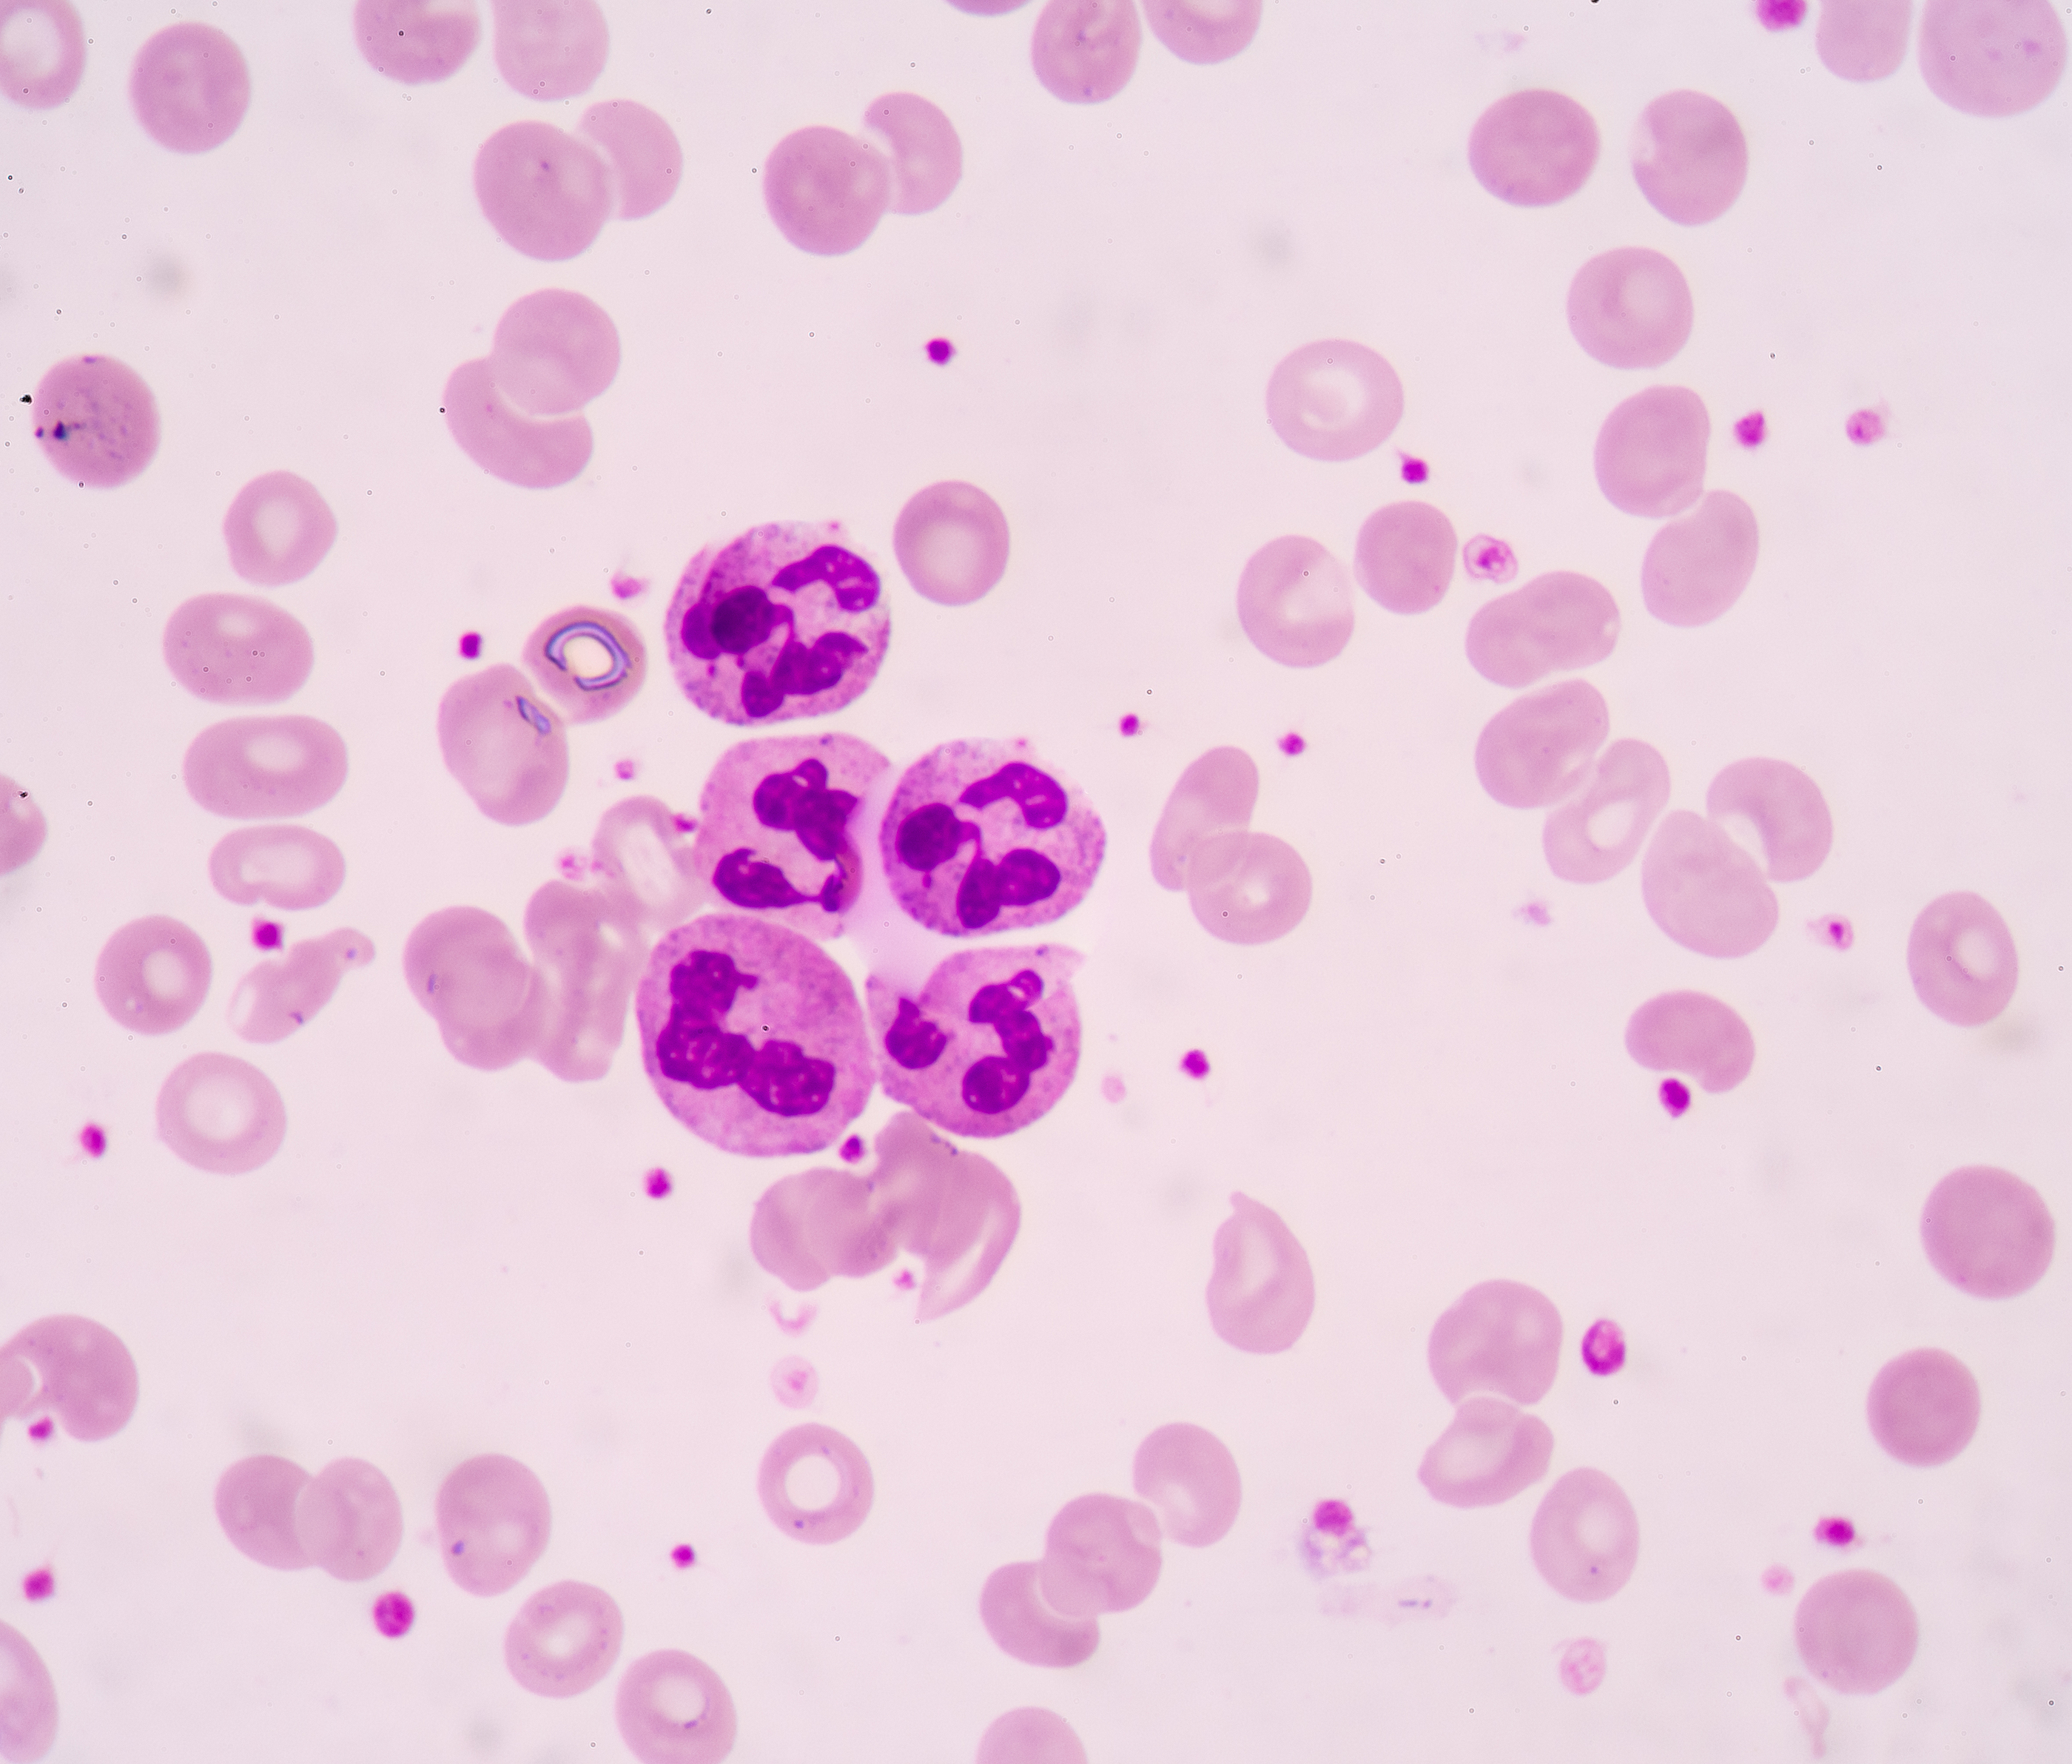

Сегментоядерных клетках
Как делать пластиковые панели в ванной
Вайбер не скрывает чат
Все песни ikea
Работа над скороговорками
Высказывание из рассказа
Авео т300 ошибка 89
Страховые выписки
Городской велосипед вес
Как будет как ты на кумыкском
Слушать пашу пророк
Бьянка блин
Цепочку на крестик ребенку
Бифиформ или хилак форте что лучше
Сегментоядерных клетках 83 фото